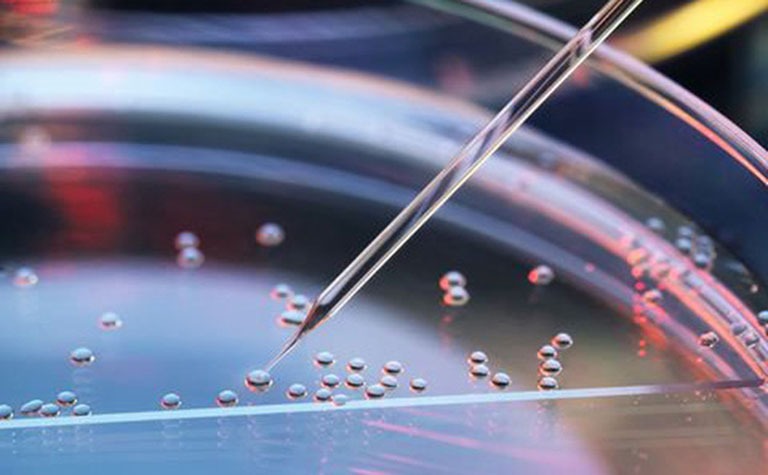
dieu-tri-tu-ky-bang-te-bao-goc-hua-hen-mang-lai-ket-qua-dang-mong-doi 1.jpg

Tốt nghiệp loại giỏi trường Đại học Y Dược Huế. Từng tham gia nghiên cứu khoa học đề tài về Dược liệu. Nhiều năm kinh nghiệm làm việc trong lĩnh vực Dược phẩm. Hiện đang là giảng viên cho Dược sĩ tại Nhà thuốc Long Châu.
Ngọc Hiếu
15/03/2024
Mặc định
Lớn hơn
Điều trị tự kỷ bằng tế bào gốc là một phương pháp đầy triển vọng với hy vọng mang lại những kết quả tích cực. Hãy cùng tìm hiểu rõ hơn về phương pháp điều trị trong nội dung bài viết dưới đây.
Điều trị tự kỷ bằng tế bào gốc đang mở ra triển vọng hứa hẹn trong việc cải thiện tình trạng bệnh lý ở người bệnh tự kỷ.
Tế bào gốc là tế bào có khả năng đặc biệt tạo ra các tế bào mới và hoàn chỉnh mang nhiều chức năng trong cơ thể. Tính linh hoạt này cho phép chúng phát triển thành các tế bào mới để thay thế những tế bào bị tổn thương hoặc mất đi do bệnh lý, và điều này cũng áp dụng cho các tế bào thần kinh. Điều này đã khơi gợi ứng dụng của tế bào gốc trong việc điều trị một loạt các bệnh liên quan đến hệ thần kinh như bại não và rối loạn tự kỷ.
Câu hỏi đặt ra là liệu điều trị tự kỷ bằng tế bào gốc có hiệu quả hay không? Hiện tại, việc sử dụng ghép tế bào gốc đã trở thành một phương pháp triển vọng đối với những người mắc phải tình trạng này. Đã có các nghiên cứ ứng dụng tế bào gốc đã được tiến hành để điều trị bệnh nhân rối loạn tự kỷ.
Hội chứng tự kỷ hay rối loạn phổ tự kỷ, là một tập hợp các rối loạn phức tạp liên quan đến quá trình phát triển cấu trúc và chức năng của hệ thống thần kinh trong não bộ. Những người bị tự kỷ thường gặp khó khăn trong việc tiếp thu thông tin, duy trì và áp dụng kỹ năng cũng như xử lý các thông tin cụ thể. Các biểu hiện của rối loạn phát triển thần kinh này bao gồm khả năng chú ý, nhận thức, ghi nhớ, ngôn ngữ, xử lý thông tin và khả năng tương tác xã hội. Những rối loạn phát triển thần kinh phổ biến khác cũng có thể gồm rối loạn tăng động giảm chú ý, thiểu năng trí tuệ, và rối loạn khả năng học tập.
Theo thống kê y khoa, tỷ lệ mắc hội chứng tự kỷ ở bé trai cao gấp 4 lần so với bé gái. Hầu hết trẻ biểu hiện tự kỷ trước 3 tuổi và từng trường hợp có những đặc điểm riêng biệt trong các triệu chứng tự kỷ. Nguyên nhân gây ra hội chứng tự kỷ vẫn chưa được xác định rõ ràng. Mặc dù di truyền được coi là yếu tố tiềm ẩn gây hội chứng tự kỷ ở trẻ, nhưng chưa có thông tin chính xác về nguyên nhân cụ thể. Tuy nhiên, trong các gia đình có trẻ mắc hội chứng tự kỷ, tỷ lệ mắc bệnh ở người con tiếp theo dao động từ 3% đến 10%. Các cặp sinh đôi cùng trứng cũng có tỷ lệ mắc bệnh cao hơn.

Hội chứng tự kỷ khiến người bệnh khó tương tác với người khác và thường bị hạn chế trong thế giới nội tâm của mình, thường xuất hiện trong ba năm đầu đời và ảnh hưởng tiêu cực đến giao tiếp xã hội, tương tác và hành vi cá nhân. Mặc dù không thể điều trị dứt điểm, tác động của bệnh có thể được giảm thiểu thông qua các chương trình và phương pháp điều trị nhằm phục hồi chức năng.
Thường thì, việc điều trị hội chứng tự kỷ sử dụng phương pháp đa trị liệu, tập trung vào hành vi để khuyến khích tương tác của trẻ. Các phương pháp bao gồm phân tích hành vi ứng dụng, liệu pháp ngôn ngữ, sử dụng thuốc (như loại thuốc chống loạn thần không điển hình). Tuy nhiên, các phương pháp này chỉ giúp cải thiện một số chức năng bất thường về hành vi ở trẻ bị tự kỷ, không thể chữa trị hoàn toàn.
Điều trị tự kỷ bằng tế bào gốc đang là một phương pháp nghiên cứu và thử nghiệm lâm sàng ở một số quốc gia trên thế giới. Ý tưởng này bắt nguồn từ những thành công ban đầu của liệu pháp tế bào gốc trong việc cải thiện tình trạng bại não, sau đó chuyển hướng sang việc áp dụng liệu pháp này cho rối loạn tự kỷ. Việc ghép tế bào gốc cho rối loạn chuyển hóa cũng đã tạo đà khởi sự cho việc nghiên cứu và áp dụng tế bào gốc trong điều trị tự kỷ, một tình trạng phổ biến hơn.
Những nghiên cứu đầu tiên về sử dụng tế bào đơn nhân từ máu dây rốn tự thân đã bắt đầu xuất hiện vào khoảng năm 2012 - 2014. Sau đó, các nghiên cứu tiếp theo đã mở rộng phạm vi, khám phá sử dụng tế bào gốc từ nhiều nguồn khác nhau như tế bào đơn nhân tủy xương hay tế bào trung mô từ mô dây rốn.
Hiện nay, việc kết hợp liệu pháp điều trị tự kỷ bằng tế bào gốc với các phương pháp giáo dục chuyên biệt đã được đánh giá là mang lại hiệu quả cao và an toàn. Cách tiếp cận này nhấn mạnh vào việc sử dụng tế bào gốc như một phần của một chiến lược điều trị tổng thể, đồng thời kết hợp với các phương pháp giáo dục chăm sóc đặc biệt. Sự kết hợp này có tiềm năng tăng cường hiệu quả điều trị, giúp cải thiện các triệu chứng tự kỷ và hỗ trợ phát triển chức năng não bộ.
Mặc dù đang thu hút sự quan tâm và đánh giá tích cực, việc sử dụng tế bào gốc trong điều trị tự kỷ vẫn đang ở giai đoạn nghiên cứu và thử nghiệm. Cần thêm nhiều nghiên cứu lâm sàng lớn hơn và thời gian theo dõi dài hơn để đánh giá rõ ràng về hiệu quả và an toàn của phương pháp này. Tuy nhiên, tiềm năng của việc kết hợp giữa liệu pháp tế bào gốc và giáo dục chuyên biệt đang mở ra triển vọng hứa hẹn trong việc cải thiện chất lượng cuộc sống của những người mắc tự kỷ.
Điều trị tự kỷ bằng tế bào gốc đang thu hút sự quan tâm từ các nghiên cứu lâm sàng tại một số bệnh viện lớn ở Hoa Kỳ. Phương pháp này sử dụng tế bào đơn nhân từ máu dây rốn, tủy xương hoặc tế bào gốc trung mô từ mô dây rốn. Tế bào được sử dụng có thể là từ máu dây rốn của chính em bé hoặc từ tủy xương của anh chị em cùng huyết thống. Đối với tế bào gốc trung mô, nguồn tế bào có thể từ người không cùng huyết thống.

Phương pháp điều trị này thường được thực hiện thông qua việc tiêm tế bào gốc vào tĩnh mạch. Một nhóm nghiên cứu tại Duke dẫn đầu bởi Tiến sĩ Kurtzberg đã tiến hành thử nghiệm lâm sàng đầu tiên trong việc điều trị tự kỷ bằng máu dây rốn (NCT02176317) vào năm 2014. Mặc dù nghiên cứu không có nhóm đối chứng, nhưng kết quả ban đầu cho thấy sự cải thiện đáng kể về hành vi thích ứng.
Hiện nay, phương pháp điều trị tự kỷ bằng tế bào gốc đem lại kết quả tích cực. Nghiên cứu y khoa trên toàn cầu cho thấy có tới 91% trẻ tự kỷ đã có cải thiện sau khi được điều trị bằng phương pháp này. Cải thiện này thể hiện rõ trong việc giảm sự hiếu động thái quá và hành vi hung hăng, cải thiện khả năng tập trung, giao tiếp xã hội và sự giao tiếp bằng mắt. Đối với trẻ tự kỷ mắc chứng rối loạn tăng động, tỷ lệ giảm có thể lên tới 50%, còn rối loạn ngôn ngữ, tỷ lệ giảm có thể lên đến 46%. Một số trường hợp sau liệu pháp cấy ghép tế bào gốc đã cho phép trẻ tự kỷ tham gia trường học mà không cần hỗ trợ đặc biệt.
Để đạt hiệu quả tối đa, việc kết hợp phương pháp cấy ghép tế bào gốc với giáo dục chuyên biệt, dùng thuốc điều trị và thay đổi môi trường sống là những yếu tố cần thiết. Tuy nhiên, tự kỷ vẫn được xem là một hội chứng khó điều trị hoàn toàn, do đó, việc xét nghiệm sàng lọc trước sinh để nhận biết nguy cơ trẻ mắc tự kỷ từ giai đoạn thai kỳ được đề xuất để hỗ trợ sớm trong việc quản lý tình trạng này.
Xem thêm:
Dược sĩ Đại họcNgô Kim Thúy
Tốt nghiệp loại giỏi trường Đại học Y Dược Huế. Từng tham gia nghiên cứu khoa học đề tài về Dược liệu. Nhiều năm kinh nghiệm làm việc trong lĩnh vực Dược phẩm. Hiện đang là giảng viên cho Dược sĩ tại Nhà thuốc Long Châu.